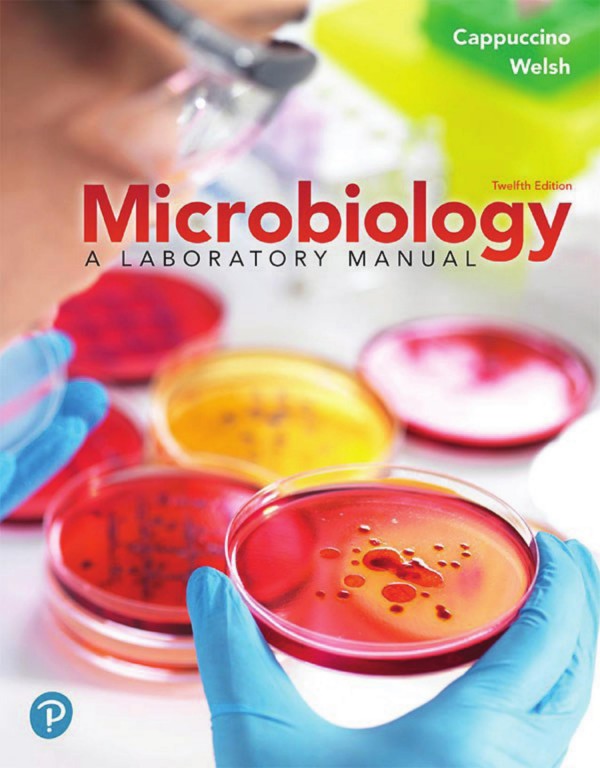

Microbiology A Laboratory Manual 12th Edition by James Cappuccino, Chad Welsh – Ebook PDF Instant Download/Delivery. 0137546521, 9780137546527
Full download Microbiology A Laboratory Manual 12th Edition after payment
Product details:
ISBN 10: 0137546521
ISBN 13: 9780137546527
Author: James Cappuccino, Chad Welsh
This is the eBook of the printed book and may not include any media, website access codes, or print supplements that may come packaged with the bound book. This loose-leaf, three-hole punched textbook that gives students the flexibility to take only what they need to class and add their own notes–all at an affordable price. For courses in Microbiology Lab and Nursing and Allied Health Microbiology Lab. Foundations in microbiology lab work with clinical and critical-thinking emphasis Microbiology: A Laboratory Manual, 12th Edition provides students with a solid underpinning of microbiology laboratory work while putting increased focus on clinical applications and critical-thinking skills, as required by today’s instructors. The text is clear, comprehensive, and versatile, easily adapted to virtually any microbiology lab course and easily paired with any undergraduate microbiology text. The 12th Edition has been extensively updated to enhance the student experience and meet instructor requirements in a shifting learning environment. Updates and additions include clinical case studies, equipment and material checklists, new experiments, governing body guidelines, and more.
Microbiology A Laboratory Manual 12th Table of contents:
Laboratory Safety Rules and Regulations
Provide New Learning Pathways to Understand the Why Behind the Science
Connect Lecture and Lab with Mastering Microbiology
And Come to Class Better Prepared for Lab
Additional Instructor Support to Customize Your Course Your Way
Microbiology A Laboratory Manual
Contents
Preface
Our Approach
Organization
New to the Twelfth Edition
Instructor Resources
Laboratory Safety
Laboratory Protocol
Part 1 Basic Laboratory Techniques for Isolation, Cultivation, and Cultural Characterization of Microorganisms
Introduction
Media
Aseptic Technique
Culture Tubes and Petri Dishes
Transfer Instruments
Cultivation Chambers
Refrigerator
Further Reading
Experiment 1 Effectiveness of Hand Washing
Learning Objectives
Principle
Further Reading
Experiment 1 Lab Report
Observations and Results
Review Questions
Experiment 2 Culture Transfer Techniques
Learning Objectives
Principle
Further Reading
Experiment 2 Lab Report
Observations and Results Culture “A”
Observations and Results Culture “B”
Observations and Results S. marcescens
Experiment 3 Techniques for Isolation of Pure Cultures
PART A Isolation of Discrete Colonies from a Mixed Culture
Learning Objective
Principle
Further Reading
PART B Isolation of Pure Cultures from a Spread-Plate or Streak-Plate Preparation
Learning Objective
Principle
Experiment 3 Lab Report
Observations and Results
PART A: Isolation of Discrete Colonies from a Mixed Culture
PART B: Isolation of Pure Cultures from a Spread-Plate or Streak-Plate Preparation
Review Questions
Experiment 4 Cultural Characteristics of Microorganisms
Learning Objective
Principle
Nutrient Agar Slants
Nutrient Agar Plates
Nutrient Broth Cultures
Nutrient Gelatin
Further Reading
Experiment 4 Lab Report
Observations and Results
Nutrient Agar Slants
Nutrient Agar Plates
Nutrient Broth Cultures
Nutrient Gelatin
Part 2 Microscopy
Introduction
Essential Features of Various Microscopes
Further Reading
Experiment 5 Microscopic Examination of Stained Cell Preparations
Learning Objectives
Principle
Components of the Microscope
Stage
Illumination
Abbé condenser
Body tube
Theoretical Principles of Microscopy
Magnification
Resolving power or resolution
Illumination
Use and Care of the Microscope
Further Reading
Experiment 5 Lab Report
Observations and Results
Review Questions
Experiment 6 Microscopic Examination of Living Microorganisms Using a Hanging-Drop Preparation or a Wet Mount
Learning Objectives
Principle
Experiment 6 Lab Report
Observations and Results
Review Questions
Part 3 Bacterial Staining
Introduction
Further Reading
Experiment 7 Preparation of Bacterial Smears
Learning Objective
Principle
Further Reading
Experiment 7 Lab Report
Observations and Results
Review Questions
Experiment 8 Simple Staining
Learning Objectives
Principle
Further Reading
Experiment 8 Lab Report
Observations and Results
Review Questions
Experiment 9 Negative Staining
Learning Objectives
Principle
Further Reading
Experiment 9 Lab Report
Observations and Results
Review Questions
Experiment 10 Gram Stain
Learning Objectives
Principle
Primary Stain
Mordant
Decolorizing Agent
Counterstain
Further Reading
Experiment 10 Lab Report
Observations and Results
Review Questions
Experiment 11 Acid-Fast Stain
Learning Objectives
Principle
Primary Stain
Decolorizing Agent
Counterstain
Further Reading
Experiment 11 Lab Report
Observations and Results
Review Questions
Experiment 12 Differential Staining for Visualization of Bacterial Cell Structures
Learning Objectives
PART A Spore Stain (Schaeffer-Fulton Method)
Principle
Primary Stain
Decolorizing Agent
Counterstain
Further Reading
PART B Capsule Stain (Anthony Method)
Principle
Primary Stain
Decolorizing Agent
Experiment 12 Lab Report
Observations and Results
PART A: Spore Stain
PART B: Capsule Stain
Review Questions
Part 4 Cultivation of Microorganisms: Nutritional and Physical Requirements, and Enumeration of Microbial Populations
Introduction
Nutritional Needs
Physical Factors
Further Reading
Experiment 13 Nutritional Requirements: Media for the Routine Cultivation of Bacteria
Learning Objectives
Principle
Chemically Defined Media
Complex Media
Measuring Turbidity
Further Reading
Experiment 13 Lab Report
Observations and Results
Optical Density Readings Using the Spectrophotometer
Optical Density Readings Using a Colorimetric Plate Reader
Review Questions
Experiment 14 Using Differential, Selective, and Enriched Media
Learning Objectives
Principle
Selective Media
Differential/Selective Media
Enriched Media
Further Reading
Experiment 14 Lab Report
Observations and Results
Review Questions
Experiment 15 Physical Factors: Temperature
Learning Objectives
Principle
Further Reading
Experiment 15 Lab Report
Observations and Results
Review Questions
Experiment 16 Physical Factors: pH of the Extracellular Environment
Learning Objective
Principle
Further Reading
Experiment 16 Lab Report
Observations and Results
Absorbance Readings
pH Summary
Review Questions
Experiment 17 Physical Factors: Atmospheric Oxygen Requirements
Learning Objective
Principle
Further Reading
Experiment 17 Lab Report
Observations and Results
Review Questions
Experiment 18 Techniques for Cultivating Anaerobic Microorganisms
Learning Objective
Principle
Further Reading
Experiment 18 Lab Report
Observations and Results
Review Questions
Experiment 19 Serial Dilution—Agar Plate Procedure to Quantitate Viable Cells
Learning Objectives
Principle
Direct Microscopic Counts
Electronic Cell Counters
Chemical Methods
Spectrophotometric Analysis
Serial Dilution–Agar Plate Analysis
Further Reading
Experiment 19 Lab Report
Observations and Results
Review Questions
Experiment 20 The Bacterial Growth Curve
Learning Objectives
Principle
Further Reading
Experiment 20 Lab Report
Observations and Results
Review Questions
Part 5 Biochemical Activities of Microorganisms
Introduction
Extracellular Enzymes (Exoenzymes)
Intracellular Enzymes (Endoenzymes)
Further Reading
Experiment 21 Extracellular Enzymatic Activities of Microorganisms
Learning Objectives
Principle
Starch Hydrolysis
Lipid Hydrolysis
Casein Hydrolysis
Gelatin Hydrolysis
Further Reading
Experiment 21 Lab Report
Observations and Results
Starch and Lipid Hydrolysis
Casein and Gelatin Hydrolysis
Review Questions
Experiment 22 Carbohydrate Fermentation
Learning Objectives
Principle
Further Reading
Experiment 22 Lab Report
Observations and Results
Review Questions
Experiment 23 Triple Sugar–Iron Agar Test
Learning Objectives
Principle
Further Reading
Experiment 23 Lab Report
Observations and Results
Review Questions
Experiment 24 IMViC Test
Further Reading
PART A Indole Production Test
Learning Objective
Principle
PART B Methyl Red Test Voges-Proskauer Test (MR-VP)
Learning Objectives
Principle
PART C Citrate Utilization Test
Learning Objective
Principle
Experiment 24 Lab Report
Observations and Results
PART A: Indole Production Test
PART B: Methyl Red Test and Voges-Proskauer Test
PART C: Citrate Utilization Test
Review Questions
Experiment 25 Hydrogen Sulfide Test
Learning Objectives
Principle
Motility
Further Reading
Experiment 25 Lab Report
Observations and Results
Review Questions
Experiment 26 Urease Test
Learning Objective
Principle
Further Reading
Experiment 26 Lab Report
Observations and Results
Review Questions
Experiment 27 Litmus–Milk Reactions
Learning Objective
Principle
Lactose Fermentation
Gas Formation
Litmus Reduction
Curd Formation
Proteolysis (Peptonization)
Alkaline Reaction
Further Reading
Experiment 27 Lab Report
Observations and Results
Review Questions
Experiment 28 Nitrate Reduction Test
Learning Objectives
Principle
Further Reading
Experiment 28 Lab Report
Observations and Results
Review Questions
Experiment 29 Catalase Test
Learning Objective
Principle
Further Reading
Experiment 29 Lab Report
Observations and Results
Review Questions
Experiment 30 Oxidase Test
Learning Objectives
Principle
Further Reading
Experiment 30 Lab Report
Observations and Results
Review Questions
Experiment 31 Utilization of Amino Acids
Further Reading
PART A Decarboxylase Test
Learning Objective
Principle
PART B Phenylalanine Deaminase Test
Learning Objective
Principle
Experiment 31 Lab Report
Observations and Results
PARTS A and B: Decarboxylase Test and Phenylalanine Deaminase Test
Review Questions
Experiment 32 Genus Identification of Unknown Bacterial Cultures
Learning Objective
Principle
Further Reading
Experiment 32 Lab Report
Observations and Results
Part 6 The Protozoa
Introduction
Further Reading
Experiment 33 Free-Living Protozoa
Learning Objective
Principle
Further Reading
Experiment 33 Lab Report
Observations and Results
Review Questions
Experiment 34 Parasitic Protozoa
Learning Objective
Principle
Further Reading
Experiment 34 Lab Report
Observations and Results
Review Questions
Part 7 The Fungi
Introduction
Further Reading
Experiment 35 Cultivation and Morphology of Molds
PART A Slide Culture Technique
Learning Objectives
Principle
Further Reading
PART B Mold Cultivation on Solid Surfaces
Learning Objectives
Principle
Experiment 35 Lab Report
Observations and Results
Part A: Slide Culture Technique
Part B: Mold Cultivation on Solid Surfaces
Review Questions
Experiment 36 Isolation of a Soil Fungal Species
Learning Objectives
Principle
Further Reading
Experiment 36 Lab Report
Observations and Results
Review Questions
Experiment 37 Yeast Morphology, Cultural Characteristics, and Reproduction
Learning Objectives
Principle
Further Reading
Experiment 37 Lab Report
Observations and Results
Morphological Characteristics
Fermentation Studies
Sexual Reproduction
Review Questions
Part 8 The Viruses
Introduction
Further Reading
Experiment 38 Cultivation and Enumeration of Bacteriophages
Learning Objective
Principle
Further Reading
Experiment 38 Lab Report
Observations and Results
Review Questions
Experiment 39 Isolation of Coliphages from Raw Sewage
Learning Objective
Principle
Further Reading
Experiment 39 Lab Report
Observations and Results
Review Questions
Experiment 40 Propagation of Isolated Bacteriophage Cultures
Learning Objectives
Principle
Further Reading
Experiment 40 Lab Report
Observations and Results
Review Questions
Part 9 Physical and Chemical Agents for the Control of Microbial Growth
Introduction
Chemical Methods for Control of Microbial Growth
Physical Methods for Control of Microbial Growth
Governing Bodies for Laboratory Procedures
Further Reading
Experiment 41 Physical Agents of Control: Moist Heat
Learning Objective
Principle
Further Reading
Experiment 41 Lab Report
Observations and Results
Review Questions
Experiment 42 Chemical Agents of Control: Chemotherapeutic Agents
Synthetic Agents
PART A The Kirby-Bauer Antibiotic Sensitivity Test Procedure
Learning Objective
Principle
Further Reading
PART B Synergistic Effect of Drug Combinations
Learning Objective
Principle
Further Reading
Experiment 42 Lab Report
Observations and Results
Part A: Kirby-Bauer Antibiotic Sensitivity Test Procedure
Part B: Synergistic Effect of Drug Combinations
Review Questions
Experiment 43 Determination of Penicillin Activity in the Presence and Absence of Penicillinase
Learning Objectives
Principle
Further Reading
Experiment 43 Lab Report
Observations and Results
Part A: MIC Determination Using a Spectrophotometer
Part B: MIC Determination Using a Plate Reader
Review Questions
Experiment 44 Chemical Agents of Control: Disinfectants and Antiseptics
PART A Disc Diffusion Testing of Disinfectants and Antiseptics
Learning Objective
Principle
Further Reading
PART B Modified-Use Dilution Testing of Disinfectants and Antiseptics
Learning Objective
Principle
Further Reading
Experiment 44 Lab Report
Observations and Results
Part A: Disc Diffusion Testing of Disinfectants and Antiseptics
Part B: Modified-Use Dilution Testing of Disinfectants and Antiseptics
Review Questions
Part 10 Microbiology of Food
Introduction
Further Reading
Experiment 45 Microbiological Analysis of Food Products: Bacterial Count
Learning Objectives
Principle
Further Reading
Experiment 45 Lab Report
Observations and Results
Review Questions
Experiment 46 Isolation of Salmonella from Raw Meat
Learning Objective
Principle
Further Reading
Experiment 46 Lab Report
Observations and Results
Review Questions
Experiment 47 Microbial Fermentation
PART A Alcohol Fermentation
Learning Objective
Principle
Further Reading
PART B Lactic Acid Fermentation
Learning Objective
Principle
Experiment 47 Lab Report
Observations and Results for Alcohol Fermentation
Observations and Results for Lactic Acid Fermentation
Review Questions
Part 11 Microbiology of Water
Introduction
Further Reading
Experiment 48 Standard Qualitative Analysis of Water
Learning Objectives
Principle
The Presumptive Test
The Confirmed Test
The Completed Test
Environmental Protection Agency
Further Reading
Experiment 48 Lab Report
Observations and Results
Presumptive Test
Confirmed Test
Completed Test
Review Questions
Experiment 49 Quantitative Analysis of Water: Membrane Filter Method
Learning Objective
Principle
Further Reading
Experiment 49 Lab Report
Observations and Results
Review Questions
Part 12 Microbiology of Soil
Introduction
Nitrogen Cycle
Carbon Cycle
Sulfur Cycle
Further Reading
Experiment 50 Microbial Populations in Soil: Enumeration
Learning Objectives
Principle
Further Reading
Experiment 50 Lab Report
Observations and Results
Review Questions
Experiment 51 Isolation of Antibiotic-Producing Microorganisms and Determination of Antimicrobial Spectrum of Isolates
Learning Objective
Further Reading
PART A Isolation of Antibiotic-Producing Microorganisms
Procedure Lab One
Procedure Lab Two
PART B Determination of Antimicrobial Spectrum of Isolates
Procedure Lab One
Procedure Lab Two
Procedure Lab Three
Experiment 51 Lab Report
Observations and Results
Part A: Isolation of Antibiotic-Producing Microorganisms
Part B: Determination of Antimicrobial Spectrum of Isolates
Review Questions
Experiment 52 Isolation of Pseudomonas Species by Means of the Enrichment Culture Technique
Learning Objective
Principle
Further Reading
Experiment 52 Lab Report
Observations and Results
Gram Reactions and Colony Characteristics
Litmus Milk Reaction
Nitrate Reduction Test
Review Questions
Part 13 Bacterial Genetics
Introduction
Further Reading
Experiment 53 Enzyme Induction
Learning Objectives
Principle
Further Reading
Experiment 53 Lab Report
Observations and Results
Review Questions
Experiment 54 Bacterial Conjugation
Learning Objective
Principle
Further Reading
Experiment 54 Lab Report
Observations and Results
Review Questions
Experiment 55 Isolation of a Streptomycin-Resistant Mutant
Learning Objective
Principle
Further Reading
Experiment 55 Lab Report
Observations and Results
Review Questions
Experiment 56 The Ames Test: A Bacterial Test System for Chemical Carcinogenicity
Learning Objective
Principle
Further Reading
Experiment 56 Lab Report
Observations and Results
Review Questions
Experiment 57 Utilization of Bacterial Plasmids
Learning Objectives
Principle
Further Reading
Experiment 57 Lab Report
Observations and Results
Review Questions
Experiment 58 Restriction Analysis and Electrophoretic Separation of Bacteriophage Lambda DNA
Learning Objectives
Principle
Further Reading
Experiment 58 Lab Report
Observations and Results
Review Questions
Part 14 Medical Microbiology
Introduction
Further Reading
Experiment 59 Microbial Flora of the Mouth: Determination of Susceptibility to Dental Caries
Learning Objectives
Principle
Further Reading
Experiment 59 Lab Report
Observations and Results
Review Questions
Experiment 60 Normal Microbial Flora of the Throat and Skin
Learning Objective
Principle
Isolation of Microbial Flora
Further Reading
Experiment 60 Lab Report
Observations and Results
Isolation of Microbial Flora
Selection and Differentiation of Skin and Throat Isolates
Staining and Morphological Characteristics of Skin and Throat Isolates
Review Questions
Experiment 61 Identification of Human Staphylococcal Pathogens
Learning Objectives
Principle
Traditional Procedures
STAPH-IDENT® System Procedure
Latex Agglutination Procedure
Further Reading
Experiment 61 Lab Report
Observations and Results
Traditional Procedures
STAPH-IDENT System Procedure
Latex Agglutination Procedure
Experiment 62 Identification of Human Streptococcal Pathogens
Learning Objectives
Principle
Further Reading
Experiment 62 Lab Report
Observations and Results
Review Questions
Experiment 63 Identification of Streptococcus Pneumoniae
Learning Objective
Principle
Further Reading
Experiment 63 Lab Report
Observations and Results
Review Questions
Experiment 64 Identification of Enteric Microorganisms Using Computer-Assisted Multitest Microsystems
Learning Objectives
Principle
Enterotube II Multitest System and ENCISE II
API (Analytical Profile Index) System
EnteroPluri-Test System
Further Reading
Experiment 64 Lab Report
Observations and Results
Review Questions
Experiment 65 Isolation and Presumptive Identification of Campylobacter
Learning Objective
Principle
Further Reading
Experiment 65 Lab Report
Observations and Results
Review Questions
Experiment 66 Microbiological Analysis of Urine Specimens
Learning Objectives
Principle
Further Reading
Experiment 66 Lab Report
Observations and Results
Bacturcult Procedure
Calibrated Loop Procedure
Review Questions
Experiment 67 Microbiological Analysis of Blood Specimens
Learning Objectives
Principle
Further Reading
Experiment 67 Lab Report
Observations and Results
Review Questions
Experiment 68 Species Identification of Unknown Bacterial Cultures
Learning Objective
Principle
Further Reading
Experiment 68 Lab Report
Observations and Results
Separation of the Bacteria in Mixed Unknown Culture
Preparation of Pure Cultures
Identification of Unknown Bacterial Species
Part 15 Immunology
Introduction
Further Reading
Experiment 69 Precipitin Reaction: The Ring Test
Learning Objective
Principle
Further Reading
Experiment 69 Lab Report
Observations and Results
Review Questions
Experiment 70 Agglutination Reaction: The Febrile Antibody Test
Learning Objective
Principle
Further Reading
Experiment 70 Lab Report
Observations and Results
Febrile Antibody Test
Serological Identification of an Unknown Organism
Determination of Antibody Titer
Review Questions
Experiment 71 Enzyme-Linked Immunosorbent Assay
Learning Objective
Principle
Further Reading
Experiment 71 Lab Report
Observations and Results
Review Question
Experiment 72 Sexually Transmitted Diseases: Rapid Immunodiagnostic Procedures
PART A Rapid Plasma Reagin Test for Syphilis
Learning Objective
Principle
PART B Genital Herpes: Isolation and Identification of Herpes Simplex Virus
Learning Objective
Principle
PART C Detection of Sexually Transmitted Chlamydial Diseases
Learning Objective
Principle
Experiment 72 Lab Report
Observations and Results
PART A: Rapid Plasma Reagin Test for Syphilis
PART B: Genital Herpes: Isolation and Identification of Herpes Simplex Virus
PART C: Detection of Sexually Transmitted Chlamydial Diseases
Review Questions
Appendices
Appendix 1 Scientific Notation
Multiplication
Division
Appendix 2 Methods for the Preparation of Dilutions
Appendix 3 Microbiological Media
Appendix 4 Biochemical Test Reagents
Appendix 5 Staining Reagents
Acid-Fast Stain
Carbol fuchsin (Ziehl’s)
Acid Alcohol
Methylene blue
Capsule Stain
Crystal violet (1%)
Copper sulfate solution (20%)
Fungal Stains
Lactophenol–cotton-blue solution
Water-iodine solution
Gram Stain
Crystal violet (Hucker’s)
Gram’s iodine
Ethyl alcohol (95%)
Safranin
Negative Stain
Nigrosin
Spore Stain
Malachite green
Safranin
Appendix 6 Experimental Microorganisms
Cultures
People also search for Microbiology A Laboratory Manual 12th:
microbiology: a laboratory manual
analytical food microbiology a laboratory manual
borrow microbiology a laboratory manual
techniques of microbiology a laboratory manual
food microbiology a laboratory manual



